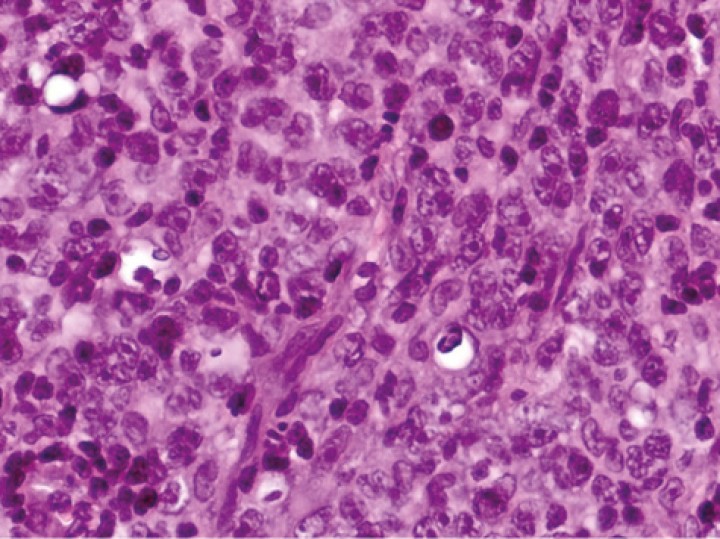
<p>Imagen del estudio histopatológico donde se observa proliferación de células redondas de medio tamaño con patrón difuso (H&E, 400x).</p>

Resumen
Se evaluó a un gato de raza común europea, macho castrado de 7 años por presentar un cuadro clínico de apatía, hiporexia y paraparesia no ambulatoria de 2 semanas de evolución. Después de la valoración neurológica, estudio de resonancia magnética (RM), estudio histopatológico e inmunohistoquímica se obtuvo un diagnóstico de linfoma espinal extradural (epidural) difuso de células B (CD20 positivo), estadio 3, el cual se trató con la combinación de cirugía y protocolo de quimioterapia adyuvante. El tiempo de supervivencia fue de 35 días.
Abstract
A 7-year-old male neutered European cat was presented with a 2-week-history of apathy, hyporexia, and non-ambulatory paraparesis. Neurological examination, magnetic resonance imaging (MRI), histopathology, and immunohistochemistry confirmed the diagnosis of stage 3 diffuse extradural (epidural) B-cell spinal lymphoma (CD20 positive) which was treated with the combination of surgery and adjuvant chemotherapy. The survival time was 35 days.

La presencia de este logo en un artículo de la revista indica que se publicará un examen sobre el mismo en la plataforma AVEPA Elearning. Su resolución aporta 0,15 créditos dentro del sistema de acreditaciones de especialidades veterinarias de AVEPA.
Introducción
El linfoma comprende un grupo diverso de neoplasias que tienen en común su origen en los linfocitos presentes en los tejidos linfoides, como los ganglios linfáticos, el bazo y la médula ósea; sin embargo, pueden aparecer en casi cualquier tejido del cuerpo.[ David M, Marie P, Karen M: Tumores hematopoyéticos. EN Withrow y MacEwen (ed): Oncología Clínica de Pequeños Animales, Missouri, Elsevier, 2020; 518-582. ]
La forma de presentación extranodal es la segunda más frecuente, después de la gastrointestinal, siendo las localizaciones más comunes la cavidad nasal, el riñón, el sistema nervioso central (SNC), laringe, tráquea, piel, tejido subcutáneo y ojo. Los signos clínicos asociados son variables y dependen de la localización y extensión de la enfermedad.[ David M, Marie P, Karen M: Tumores hematopoyéticos. EN Withrow y MacEwen (ed): Oncología Clínica de Pequeños Animales, Missouri, Elsevier, 2020; 518-582. , Mandara MT, Motta L, Calò P. Distribution of feline lymphoma in the central and peripheral nervous systems. Vet J 2016; 216: 109-116. [PubMed] ]
De los diferentes tipos de tumor que afectan a la médula espinal felina, el linfoma es el tipo de cáncer más común (spinal cord lymphoma-SCL)[ Marioni-Henry K, Van Winkle TJ, Smith SH et al.: Tumors affecting the spinal cord of cats: 85 cases (1980-2005). J Am Vet Med Assoc 2008; 232: 237-243. [PubMed] , Marioni-Henry K, Vite CH, Newton AL et al.: Prevalence of diseases of the spinal cord of cats. J Vet Intern Med 2004; 18: 851-858. [PubMed] , Marioni-Henry K. Feline spinal cord diseases. Vet Clin North Am Small Anim Pract 2010; 40(5): 1011-1028. [PubMed] ] y, aunque comúnmente se desarrolla en la médula espinal como parte de un proceso multicéntrico, puede ocurrir una forma primaria. Las lesiones espinales suelen ser tanto extradurales como intradurales (limitándose a uno u otro espacio).[ Mandara MT, Motta L, Calò P. Distribution of feline lymphoma in the central and peripheral nervous systems. Vet J 2016; 216: 109-116. [PubMed] ]
El linfoma primario del SNC representa menos del 3 % de todos los tumores primarios de encéfalo y de médula espinal en gatos.[ Rissi DR. A review of primary central nervous system neoplasms of cats. Vet Pathol 2023; 60(3): 294-307. [PubMed] ]
Los signos clínicos asociados al SCL pueden ser tanto inespecíficos (hiporexia, letargia) como signos relacionados con su localización (paresis, plejía, ataxia propioceptiva y dolor a la palpación).[ Mandara MT, Motta L, Calò P. Distribution of feline lymphoma in the central and peripheral nervous systems. Vet J 2016; 216: 109-116. [PubMed] , Marioni-Henry K, Van Winkle TJ, Smith SH et al.: Tumors affecting the spinal cord of cats: 85 cases (1980-2005). J Am Vet Med Assoc 2008; 232: 237-243. [PubMed] , Marioni-Henry K, Vite CH, Newton AL et al.: Prevalence of diseases of the spinal cord of cats. J Vet Intern Med 2004; 18: 851-858. [PubMed] , Marioni-Henry K. Feline spinal cord diseases. Vet Clin North Am Small Anim Pract 2010; 40(5): 1011-1028. [PubMed] , Spodnick GJ, Berg J, Moore FM et al.: Spinal lymphoma in cats: 21 cases (1976-1989). J Am Vet Med Assoc 1992; 200: 373-376. [PubMed] ]
A pesar de una aparente predisposición en gatos jóvenes (4,5-10,5 años) y positivos al virus de la leucemia felina (FeLV),[ Mandara MT, Motta L, Calò P. Distribution of feline lymphoma in the central and peripheral nervous systems. Vet J 2016; 216: 109-116. [PubMed] , Marioni-Henry K, Vite CH, Newton AL et al.: Prevalence of diseases of the spinal cord of cats. J Vet Intern Med 2004; 18: 851-858. [PubMed] , Troxel MT, Vite CH, Van Winkle TJ et al.: Feline intracranial neoplasia: retrospective review of 160 cases (1985-2001). J Vet Intern Med 2003; 17: 850-859. [PubMed] ] existe una amplia distribución por edad siendo la prevalencia variable según los estudios.
Caso clínico
Acude a consulta un gato, común europeo, macho castrado de 7 años, por presentar un cuadro clínico de apatía, hiporexia y paraparesia no ambulatoria. El proceso comenzó 2 semanas atrás con una cojera intermitente de la extremidad posterior izquierda y debilidad del tercio posterior que respondió inicialmente al tratamiento médico, basado en antiinflamatorios no esteroides y reposo, para posteriormente experimentar un empeoramiento agudo del proceso.
El examen neurológico evidenció paraparesia no ambulatoria y retraso en las reacciones posturales de ambas extremidades posteriores, más marcado en la extremidad posterior izquierda (EPI) (Fig.1). Los reflejos patelar, flexor y perineal estaban disminuidos y la nocicepción, intacta. El paciente presentaba parálisis de la cola con pérdida de nocicepción. La exploración de los pares craneales y las extremidades anteriores fue normal. No se detectó dolor espinal durante la evaluación. El examen neurológico fue compatible con una lesión localizada entre los segmentos espinales L4-S3.

Gato común europeo macho castrado de 7 años con pérdida del tono muscular de la cola y ausencia de propiocepción en ambas extremidades pélvicas.
Las pruebas diagnósticas realizadas incluyeron análisis de sangre, radiografía laterolateral de tórax y ecografía abdominal, sin resultar en alteraciones significativas. La serología frente al virus de la leucemia e inmunodeficiencia felina resultó positiva para esta última. En el estudio de resonancia magnética (RM; Fig. 2) de la región toracolumbosacra (Toshiba Vantage Elan 1.5 T: Adquisición de planos transversal, sagital y coronal ponderados en T1 pre y post-contraste intravenoso con gadolinio, así como planos ponderados en T2 y STIR) se cuentan 6 vértebras lumbares, lo cual es compatible con anatomía de transición en la región lumbar, como hallazgo incidental. En el lado izquierdo del canal vertebral, desde el tercio craneal de la vértebra L5 hasta el tercio caudal de la vértebra L6 se encuentra una lesión con aspecto alargado y de base ancha, con márgenes mal definidos e irregulares, distribución posiblemente extradural y/o intradural/extramedular, causando compresión severa de la médula espinal, que aparece desplazada hacia el lado derecho. En cuanto al patrón de intensidad de la señal, este fue hiperintenso de forma homogénea en las secuencias ponderadas en T2 e isointenso en las secuencias ponderadas en T1, con un realce homogéneo y focal en la región media de la vértebra L6. La lesión se extiende parcialmente en el foramen intervertebral izquierdo entre las vértebras L5 y L6 y se aprecia siringomielia leve, que puede ser un proceso secundario a la compresión de la médula espinal por parte de la lesión, más caudalmente a nivel lumbar.

Imágenes de RM postcontraste en las que se identifica una lesión de forma alargada y ancha en su base, con distribución posiblemente extradural y/o intradural/extramedular a nivel de la vértebra L6 (flechas rojas). (A) Secuencia dorsal en STIR. (B) Secuencia transversal en T2. Nótese la compresión severa a la que es sometida la médula espinal (flecha verde). (C) Secuencia transversal en T1 precontraste. (D) Secuencia transversal en T1 postcontraste. M: masa; SC: médula espinal; R: derecha; L: izquierda.
El diagnóstico diferencial incluye procesos neoplásicos, como meningioma, linfoma o un tumor de la vaina mielínica como opciones más probables, siendo un origen inflamatorio de la lesión poco probable.
A continuación, se realizó una cirugía espinal consistente en hemilaminectomía para extirpar una masa extradural a nivel de las vértebras L5-L6 lateralizada hacia la izquierda, lográndose así la descompresión tanto de la médula espinal como de todas las raíces nerviosas. Se realizó durotomía debido a la dificultad en diferenciar el límite entre la neoplasia y el tejido sano, permitiendo así poder ser eliminado en su totalidad. Se confirmó la ausencia de tejido neoplásico en el espacio intradural. El aspecto macroscópico de la lesión era de una masa discreta, blanda, gris, finamente nodular (Fig. 3).

Aspecto macroscópico de la lesión.
El informe de histopatología evidenció la presencia de una proliferación neoplásica de células redondas de mediano a gran tamaño que poseían un núcleo redondeado o arriñonado, a veces con un nucléolo prominente, y citoplasma de tinción débil (Fig. 4). Las células tumorales proliferaban con un patrón difuso. El grado de atipia celular era bajo mientras que el contaje mitótico se encontraba elevado (23 mitosis/10 campos HPM). El posterior estudio inmunohistoquímico dio como resultado inmunorreactividad positiva en >95 % de las células linfoides neoplásicas para CD20 y del 2 % para CD3 (Fig. 5).
Imagen del estudio histopatológico donde se observa proliferación de células redondas de medio tamaño con patrón difuso (H&E, 400x).

Inmunotipificación del tumor, positivo en más del 95 % de las células linfoides neoplásicas (CD20, 200x).
El diagnóstico definitivo fue SCL extradural (epidural) difuso de células B (CD20 positivo), en estadio 3 según el sistema de estadificación clínica en gatos con linfoma.[ Mooney SC, Hayes AA: Lymphoma in the cat: an approach to diagnosis and management. Semin Vet Med Surg (Small Anim) 1986; 1: 51-57. [PubMed] ]
Después de la cirugía, el paciente permaneció hospitalizado durante las siguientes 72 horas para el control del dolor. Durante este período, se observó un empeoramiento transitorio de su estado neurológico, posiblemente debido a la inflamación asociada al procedimiento quirúrgico. Se implementó un tratamiento médico que incluyó prednisolona (Prednicortone® 20 mg, Dechra, Badel, Países Bajos) a una dosis de 2 mg/kg al día por vía oral (PO), buprenorfina (Buprecare® 0,3 mg/ml solución inyectable para perros y gatos, Ecuphar NV, Legeweg 157-i, 8020 Oostkamp, Bélgica) a una dosis de 0,02 mg/kg cada 8 horas vía transmucosa oral (OTM) y cefazolina (Cefazolina Normon® 1g polvo y disolvente para solución inyectable, Madrid, España) a una dosis de 20 mg/kg cada 8 horas vía intravenosa (IV). En las dos semanas posteriores, el paciente experimentó una mejoría manifiesta en su estado neurológico con respecto a su condición previa a la cirugía, recuperando parte de la movilidad de la extremidad posterior derecha y, con ello, la ambulación. Una vez se obtuvo el informe de histopatología, se aconsejó instaurar un protocolo de quimioterapia adyuvante; Entre las diferentes opciones los propietarios optaron por un protocolo de administración oral en casa a base de lomustina (Lomustine 40 mg®, Medac, Wedel, Germany) 50 mg/m2 PO cada 3-6 semanas según efectos secundarios, y prednisolona (Prednicortone® 20 mg, Dechra, Badel, Países Bajos) a 2 mg/kg cada 24 horas PO.
Cinco semanas después de realizarse la cirugía, el paciente experimentó un deterioro de evolución rápida en su estado neurológico, caracterizado por apatía, paraparesia no ambulatoria, pérdida del control voluntario de la micción y estreñimiento, por lo cual los propietarios decidieron realizar la eutanasia humanitaria. El estudio post mortem del paciente no fue realizado.
Discusión
El linfoma primario del SNC representa menos del 3 % de todos los tumores primarios de cerebro y médula espinal en gatos.[ Rissi DR. A review of primary central nervous system neoplasms of cats. Vet Pathol 2023; 60(3): 294-307. [PubMed] ] En el 90 % de los casos de linfomas felinos que afectan al SNC, la localización se encuentra en la médula espinal.[ Mandara MT, Motta L, Calò P. Distribution of feline lymphoma in the central and peripheral nervous systems. Vet J 2016; 216: 109-116. [PubMed] , Lane SB, Kornegay JN, Duncan JR et al.: Feline spinal lymphosarcoma: a retrospective evaluation of 23 cats. J Vet Intern Med 1994; 8: 99-104. [PubMed] ] Según dos estudios retrospectivos de gatos con tumores localizados en la médula espinal, el linfosarcoma es el tipo más común (28 %-40 %), seguido del osteosarcoma (16,5 %-27,5 %).[ Marioni-Henry K, Van Winkle TJ, Smith SH et al.: Tumors affecting the spinal cord of cats: 85 cases (1980-2005). J Am Vet Med Assoc 2008; 232: 237-243. [PubMed] , Marioni-Henry K, Vite CH, Newton AL et al.: Prevalence of diseases of the spinal cord of cats. J Vet Intern Med 2004; 18: 851-858. [PubMed] , Marioni-Henry K. Feline spinal cord diseases. Vet Clin North Am Small Anim Pract 2010; 40(5): 1011-1028. [PubMed] ] El SCL se presenta más comúnmente como parte de un proceso multicéntrico, con frecuente afectación renal o de la médula ósea.[ Mandara MT, Motta L, Calò P. Distribution of feline lymphoma in the central and peripheral nervous systems. Vet J 2016; 216: 109-116. [PubMed] , Valli VE, Bienzle D, Meuten DJ. Tumors of the hemolymphatic system. En Meuten DJ (ed): Tumors in Domestic Animals. 5th ed. IA: John Wiley and Sons, 2017; 203-321. ] El linfoma felino primario, originado y restringido a la médula espinal, tiene localización predominantemente extradural;[ Marioni-Henry K. Feline spinal cord diseases. Vet Clin North Am Small Anim Pract 2010; 40(5): 1011-1028. [PubMed] , Spodnick GJ, Berg J, Moore FM et al.: Spinal lymphoma in cats: 21 cases (1976-1989). J Am Vet Med Assoc 1992; 200: 373-376. [PubMed] , Lorenzo V, Ribeiro J, Bernardini M, et al.: Clinical and magnetic resonance imaging features, and pathological findings of spinal lymphoma in 27 cats. Sci 2022; 9: 980414. [PubMed] ] en raras ocasiones ocurre como un tumor intramedular que transforma la arquitectura parenquimatosa.[ Marioni-Henry K, Van Winkle TJ, Smith SH et al.: Tumors affecting the spinal cord of cats: 85 cases (1980-2005). J Am Vet Med Assoc 2008; 232: 237-243. [PubMed] ] El linfoma extradural generalmente se manifiesta como una masa discreta, de consistencia blanda, color gris, homogénea o finamente nodular. Esta masa está compuesta por una colección no encapsulada de células linfoides neoplásicas en la grasa epidural, generalmente asociada a una compresión severa de la médula. En algunos casos, la masa puede extenderse a través de los cuerpos vertebrales o hacia el músculo esquelético subyacente, incluso invadiendo la duramadre y el parénquima de la médula espinal.[ Zaki FA, Hurvitz AI: Spontaneous neoplasms of the central nervous system of the cat. J Small Anim Pract 1976; 17(12): 773-782. [PubMed] ] En contraste, el linfoma intradural-extramedular se presenta como una masa no delimitada que reemplaza los espacios subdurales y subaracnoideos, y comúnmente infiltra el parénquima de la médula espinal o las raíces nerviosas.[ Marioni-Henry K, Van Winkle TJ, Smith SH et al.: Tumors affecting the spinal cord of cats: 85 cases (1980-2005). J Am Vet Med Assoc 2008; 232: 237-243. [PubMed] , Marioni-Henry K, Vite CH, Newton AL et al.: Prevalence of diseases of the spinal cord of cats. J Vet Intern Med 2004; 18: 851-858. [PubMed] , Valli VE, Bienzle D, Meuten DJ. Tumors of the hemolymphatic system. En Meuten DJ (ed): Tumors in Domestic Animals. 5th ed. IA: John Wiley and Sons, 2017; 203-321. , Zaki FA, Hurvitz AI: Spontaneous neoplasms of the central nervous system of the cat. J Small Anim Pract 1976; 17(12): 773-782. [PubMed] , Rissi DR, McHale BJ, Miller AD: Primary nervous system lymphoma in cats. J Vet Diagn Invest 2022; 20: 10406387221090281. [PubMed] , Palus V, Volk HA, Lamb CR, Targett MP, Cherubini GB: MRI features of CNS lymphoma in dogs and cats. Vet Radiol Ultrasound 2012; 53: 44-49. [PubMed] ] Los linfomas intraparenquimatosos se caracterizan por la infiltración de células neoplásicas de la sustancia gris y blanca o espacios perivasculares parenquimatosos.[ Rissi DR, McHale BJ, Miller AD: Primary nervous system lymphoma in cats. J Vet Diagn Invest 2022; 20: 10406387221090281. [PubMed] ]
El SCL se manifiesta de manera focal, del 76 %10 al 95,6 %, presentándose como una lesión única que puede expandirse a más de un cuerpo vertebral. También puede presentarse de manera multifocal, como dos o más lesiones separadas.[ Marioni-Henry K, Vite CH, Newton AL et al.: Prevalence of diseases of the spinal cord of cats. J Vet Intern Med 2004; 18: 851-858. [PubMed] ] Tiene una marcada predilección por las regiones lumbar[ Marioni-Henry K, Vite CH, Newton AL et al.: Prevalence of diseases of the spinal cord of cats. J Vet Intern Med 2004; 18: 851-858. [PubMed] , Lorenzo V, Ribeiro J, Bernardini M, et al.: Clinical and magnetic resonance imaging features, and pathological findings of spinal lymphoma in 27 cats. Sci 2022; 9: 980414. [PubMed] , Durand A, Keenihan E, Schweizer D, et al.: Clinical and magnetic resonance imaging features of lymphoma involving the nervous system in cats. J Vet Intern Med 2022; 36: 679-693. [PubMed] ] y torácica,[ Lane SB, Kornegay JN, Duncan JR et al.: Feline spinal lymphosarcoma: a retrospective evaluation of 23 cats. J Vet Intern Med 1994; 8: 99-104. [PubMed] , Durand A, Keenihan E, Schweizer D, et al.: Clinical and magnetic resonance imaging features of lymphoma involving the nervous system in cats. J Vet Intern Med 2022; 36: 679-693. [PubMed] ] o ambas.[ Mandara MT, Motta L, Calò P. Distribution of feline lymphoma in the central and peripheral nervous systems. Vet J 2016; 216: 109-116. [PubMed] , Mello LS, Leite-Filho RV, Panziera W, et al.: Feline lymphoma in the nervous system: pathological, immunohistochemical, and etiological aspects in 16 cats. Pesq Vet Bras 2019; 39: 393-401. ]
Tradicionalmente, el SCL se consideraba una neoplasia juvenil en gatos.[ Spodnick GJ, Berg J, Moore FM et al.: Spinal lymphoma in cats: 21 cases (1976-1989). J Am Vet Med Assoc 1992; 200: 373-376. [PubMed] , Troxel MT, Vite CH, Van Winkle TJ et al.: Feline intracranial neoplasia: retrospective review of 160 cases (1985-2001). J Vet Intern Med 2003; 17: 850-859. [PubMed] ] Sin embargo, se han documentado hallazgos que sugieren una distribución bimodal en la edad de presentación de los gatos afectados, con un grupo menores de 3 años y otro con edades superiores a 8 años.[ Lorenzo V, Ribeiro J, Bernardini M, et al.: Clinical and magnetic resonance imaging features, and pathological findings of spinal lymphoma in 27 cats. Sci 2022; 9: 980414. [PubMed] , Mello LS, Leite-Filho RV, Panziera W, et al.: Feline lymphoma in the nervous system: pathological, immunohistochemical, and etiological aspects in 16 cats. Pesq Vet Bras 2019; 39: 393-401. ]
En cuanto a la relación con el FeLV, la prevalencia muestra variaciones según los estudios. Se ha observado una conexión entre la distribución bimodal en la edad y el FeLV en el linfoma felino, destacando que los gatos menores de 3 años están significativamente vinculados con la infección por FeLV, mientras que los gatos mayores de 8 años tienden a estar generalmente libres de dicha infección.[ Lorenzo V, Ribeiro J, Bernardini M, et al.: Clinical and magnetic resonance imaging features, and pathological findings of spinal lymphoma in 27 cats. Sci 2022; 9: 980414. [PubMed] , Mello LS, Leite-Filho RV, Panziera W, et al.: Feline lymphoma in the nervous system: pathological, immunohistochemical, and etiological aspects in 16 cats. Pesq Vet Bras 2019; 39: 393-401. ]
La presentación clínica es generalmente aguda a subaguda con progresión rápida. El signo clínico inicial más comúnmente observado es la paraparesia progresiva, aunque en un 3,7 % de los casos, la cojera fue la queja inicial.[ Marioni-Henry K, Vite CH, Newton AL et al.: Prevalence of diseases of the spinal cord of cats. J Vet Intern Med 2004; 18: 851-858. [PubMed] ] Además, signos inespecíficos como anorexia, letargo y pérdida de peso a menudo preceden a los signos neurológicos. El examen neurológico puede revelar molestias en la palpación de los músculos paraespinales, así como déficits neurológicos asimétricos, paresia, plejía y, con menor frecuencia, disfunción de la vejiga urinaria y pérdida de la percepción del dolor profundo.[ Mandara MT, Motta L, Calò P. Distribution of feline lymphoma in the central and peripheral nervous systems. Vet J 2016; 216: 109-116. [PubMed] ] El SCL puede presentar desafíos en su diferenciación de otros trastornos de la médula espinal.
Se puede establecer un diagnóstico antemortem presuntivo de linfoma espinal basado en datos de RM.[ Marioni-Henry K, Vite CH, Newton AL et al.: Prevalence of diseases of the spinal cord of cats. J Vet Intern Med 2004; 18: 851-858. [PubMed] ] Los SCL se manifestaron con mayor frecuencia como una lesión epidural lumbar/lumbosacra, circunferencial a la médula espinal, hiperintensa en las imágenes ponderadas en T2 e isointensa en las imágenes ponderadas en T1, con grados variables de realce posterior al contraste y compromiso óseo. La ausencia de hiperintensidad en la señal ponderada en T2 aumentaba la probabilidad de presencia de necrosis en los estudios histopatológicos, identificándola como un factor pronóstico desfavorable. En la mayoría de los casos, las lesiones eran focales (81,5 %), pero tendían a extenderse a más de un cuerpo vertebral (66,6 %).[ Sato H, Yasuhito F, Junko C et al.: Prognostic analyses on anatomical and morphological classification of feline lymphoma. J Vet Med Sci 2014; 76: 807-811. [PubMed] ] Los hallazgos de los estudios de RM en cuanto a la localización y distribución de la/s lesión/es fueron muy valiosos para la planificación de la toma de muestras.[ Lorenzo V, Ribeiro J, Bernardini M, et al.: Clinical and magnetic resonance imaging features, and pathological findings of spinal lymphoma in 27 cats. Sci 2022; 9: 980414. [PubMed] ]
El diagnóstico antemortem definitivo se puede llevar a cabo mediante citología del líquido cefalorraquídeo (LCR), la biopsia quirúrgica, punción con aguja fina o una combinación de citología e histopatología.[ Lorenzo V, Ribeiro J, Bernardini M, et al.: Clinical and magnetic resonance imaging features, and pathological findings of spinal lymphoma in 27 cats. Sci 2022; 9: 980414. [PubMed] ] El porcentaje de casos diagnosticados mediante el estudio del LCR varía en función de la bibliografía consultada (14,8 %-21,2 %).[ Marioni-Henry K, Van Winkle TJ, Smith SH et al.: Tumors affecting the spinal cord of cats: 85 cases (1980-2005). J Am Vet Med Assoc 2008; 232: 237-243. [PubMed] , Lorenzo V, Ribeiro J, Bernardini M, et al.: Clinical and magnetic resonance imaging features, and pathological findings of spinal lymphoma in 27 cats. Sci 2022; 9: 980414. [PubMed] , Durand A, Keenihan E, Schweizer D, et al.: Clinical and magnetic resonance imaging features of lymphoma involving the nervous system in cats. J Vet Intern Med 2022; 36: 679-693. [PubMed] ] En el caso de un LCR no diagnóstico, la punción con aguja fina o la biopsia quirúrgica tienen mayor valor diagnóstico.[ Lorenzo V, Ribeiro J, Bernardini M, et al.: Clinical and magnetic resonance imaging features, and pathological findings of spinal lymphoma in 27 cats. Sci 2022; 9: 980414. [PubMed] ]
La estadificación pronóstica del linfoma felino, basada en la localización y distribución de la lesión, clasifica todos los tumores paraespinales o epidurales independientemente de otros sitios tumorales como estadio III, y la afectación inicial del SNC y/o la médula ósea en estadio V.[ Mooney SC, Hayes AA: Lymphoma in the cat: an approach to diagnosis and management. Semin Vet Med Surg (Small Anim) 1986; 1: 51-57. [PubMed] , Lorenzo V, Ribeiro J, Bernardini M, et al.: Clinical and magnetic resonance imaging features, and pathological findings of spinal lymphoma in 27 cats. Sci 2022; 9: 980414. [PubMed] ] Esta clasificación, compartida entre gatos, perros y humanos, refleja la amplia variación en tipos y grados de linfomas, resultando en un comportamiento biológico diverso y respuestas variadas al tratamiento.[ Morrison WB, McCaw D, Cotter S, Ogilvie G, Moore A: The histologic classification of 602 cases of feline lymphoproliferative disease using the National Cancer Institute working formulation. J Vet Diagn Invest 2000; 12(4): 295-306. [PubMed] ] Aunque existen estudios que destacan estas variaciones en linfomas de células T, B y NK, así como en linfomas del sistema nervioso de bajo y alto grado,[ Mandara MT, Motta L, Calò P. Distribution of feline lymphoma in the central and peripheral nervous systems. Vet J 2016; 216: 109-116. [PubMed] ] la falta de investigaciones exhaustivas resalta la necesidad de más estudios en linfomas felinos. Estos estudios podrían facilitar la clasificación en patrones anatómicos y subtipos citológicos,[ Sato H, Yasuhito F, Junko C et al.: Prognostic analyses on anatomical and morphological classification of feline lymphoma. J Vet Med Sci 2014; 76: 807-811. [PubMed] ] permitiendo la categorización y desarrollo de perfiles de pronóstico individualizados.[ Moore A: Extranodal Lymphoma in the Cat: Prognostic factors and treatment options. J Feline Med Surg 2013; 15(5): 379-390. [PubMed] ]
En cuanto a la elección del tratamiento, la cirugía ha desempeñado un papel crucial como el principal enfoque terapéutico en la medicina humana para abordar los linfomas espinales epidurales primarios que comprimen la médula espinal. En el caso de enfermedad metastásica, la intervención quirúrgica se limita a la descompresión espinal y la obtención de biopsias, mientras que el manejo de la enfermedad remanente se realiza mediante una combinación estratégica de radioterapia y quimioterapia. Este enfoque integral busca maximizar la eficacia del tratamiento y mejorar los resultados clínicos.[ Cugati G, Singh M, Pande A, et al.: Primary spinal epidural lymphomas. J Craniovertebr Junction Spine 2011; 2: 3-11. [PubMed] ]
En medicina veterinaria, la información publicada acerca de las diversas opciones de tratamiento para el linfoma espinal primario es limitada. En el manejo de gatos con linfomas extraganglionares o solitarios, se han documentado casos de cura después de la extirpación quirúrgica o irradiación de linfomas solitarios, aunque estas situaciones son extremadamente raras. Las opciones de tratamiento incluyen el uso de quimioterapia o la combinación de cirugía o radioterapia con protocolos de quimioterapia, ya que los linfomas solitarios tienden a volverse sistémicos o recidivar en la mayoría de los pacientes.[ Lane SB, Kornegay JN, Duncan JR et al.: Feline spinal lymphosarcoma: a retrospective evaluation of 23 cats. J Vet Intern Med 1994; 8: 99-104. [PubMed] , Couto CG: Avances en el tratamiento del gato con linfoma en la práctica. Revista de Medicina y Cirugía Felina 2000; 2(2): 95-100. , Elmslie RE, Ogilvie GK, Gillette EL, McChesney-Gillette S: Radiotherapy with and without chemotherapy for localized lymphoma in 10 cats. Vet Radiol 1991; 32: 277-280. ] La radioterapia se destaca como una modalidad de tratamiento excelente para pacientes con linfomas solitarios, especialmente beneficiosa en los linfomas del sistema nervioso central. Aunque la mayoría de los estudios se centran en el uso de la radioterapia en el tratamiento de linfomas nasales, su eficacia se ha observado en diversos contextos clínicos.[ Lane SB, Kornegay JN, Duncan JR et al.: Feline spinal lymphosarcoma: a retrospective evaluation of 23 cats. J Vet Intern Med 1994; 8: 99-104. [PubMed] , Couto CG: Avances en el tratamiento del gato con linfoma en la práctica. Revista de Medicina y Cirugía Felina 2000; 2(2): 95-100. , Elmslie RE, Ogilvie GK, Gillette EL, McChesney-Gillette S: Radiotherapy with and without chemotherapy for localized lymphoma in 10 cats. Vet Radiol 1991; 32: 277-280. , Meleo KA. The role of radiotherapy in the treatment of lymphoma and thymoma. Vet Clin North Am Small Anim Pract 1997; 27(1): 115-129. [PubMed] ]
Hay poca información específica sobre las respuestas de los gatos con linfoma extraganglionar a la quimioterapia, siendo los protocolos COP y Wisconsin-Madison (WM) los más utilizados. En un estudio retrospectivo de 110 gatos diagnosticados con linfoma extraganglionar tratados con quimioterapia, los casos con linfoma del SNC (7/15) presentaban las tasas de respuesta y los tiempos medios de supervivencia más bajos. El escaso número de individuos no hizo posible evaluar cualquier efecto de la adición de medicamentos que penetran en el SNC, como citarabina y lomustina.[ Taylor SS, Goodfellow MR, Browne WJ, et al.: Feline extranodal lymphoma: response to chemotherapy and survival in 110 cats. J Small Anim Pract 2009; 50(11): 584-592. [PubMed] ]
La lomustina es un agente alquilante monofuncional de nitrosourea, la cual, debido a su alta solubilidad en lípidos y su relativa falta de ionización a pH fisiológico, es uno de los pocos agentes de quimioterapia que se sabe que cruza la barrera hematoencefálica. Existe poca información sobre el uso seguro y eficaz de lomustina en gatos con tumores, pero en general tiene una eficacia y seguridad aceptables para su uso en el linfoma felino.[ Fan TM, Kitchell BE, Dhaliwal RS, et al.: Hematological toxicity and therapeutic efficacy of lomustine in 20 tumor-bearing cats: critical assessment of a practical dosing regimen. J Am Anim Hosp Assoc 2002; 38(4): 357-363. [PubMed] , Rassnick KM, Gieger TL, Williams LE, et al.: Phase I evaluation of CCNU (lomustine) in tumor-bearing cats. J Vet Intern Med 2001; 15(3): 196-199. [PubMed] , Dutelle AL, Bulman-Fleming JC, Lewis CA, Rosenberg MP: Evaluation of lomustine as a rescue agent for cats with resistant lymphoma. J Feline Med Surg 2012; 14(10): 694-700. [PubMed] , Rau SE, Burgess KE: A retrospective evaluation of lomustine (CeeNU) in 32 treatment naïve cats with intermediate to large cell gastrointestinal lymphoma (2006-2013). Vet Comp Oncol 2017; 15(3): 1019-1028. [PubMed] ]
En lo que respecta a la correlación entre el tratamiento y la supervivencia, parece que la combinación de laminectomía con quimioterapia y radioterapia postoperatoria ofrece resultados prometedores, aunque hasta ahora solo se han reportado casos aislados. En un estudio retrospectivo que incluyó a 21 gatos con linfoma espinal, se observó una remisión prolongada de 62 semanas en un caso tratado con laminectomía y quimioterapia postoperatoria. Estos hallazgos sugieren la eficacia potencial de esta combinación terapéutica, subrayando la necesidad de investigaciones adicionales para confirmar y ampliar estos resultados.[ Spodnick GJ, Berg J, Moore FM et al.: Spinal lymphoma in cats: 21 cases (1976-1989). J Am Vet Med Assoc 1992; 200: 373-376. [PubMed] ]
En el caso aquí descrito, el paciente presentó un cuadro neurológico atribuible a la localización de la masa, así como signos inespecíficos. La edad de presentación del paciente entra dentro de una distribución bimodal ya descrita, aunque se reconoce la distribución variable del SCL en gatos. La radiografía laterolateral de tórax y ecografía abdominal no mostraron alteraciones significativas; sin embargo, esto no descarta la presencia de células neoplásicas en otros órganos como el bazo, el riñón o el hígado. Debido a que el tratamiento de elección consistió en la exéresis del tumor y que la biopsia quirúrgica tiene mayor valor diagnóstico que el examen del LCR, este último no se llevó a cabo. La cirugía permitió el diagnóstico definitivo, así como su completa retirada seguido del tratamiento específico de quimioterapia. A pesar de la breve supervivencia del paciente, el tiempo de supervivencia se encuentra dentro de los descritos. La ausencia de un estudio post mortem impide corroborar el deterioro neurológico secundario a una recidiva de la masa, si bien se considera lo más probable.
Agradecimientos
Los autores quieren agradecer al Dr. Mario Encinoso Quintana (Hospital Clínico Veterinario de la Universidad de Las Palmas de Gran Canaria) por su asesoramiento.
Fuente de financiación: este trabajo no se realizó con fondos comerciales, públicos o del sector privado.
Conflicto de intereses: los autores declaran que no existen conflicto de intereses.
Bibliografía
- [1] David M, Marie P, Karen M: Tumores hematopoyéticos. EN Withrow y MacEwen (ed): Oncología Clínica de Pequeños Animales, Missouri, Elsevier, 2020; 518-582.
- [2] Mandara MT, Motta L, Calò P. Distribution of feline lymphoma in the central and peripheral nervous systems. Vet J 2016; 216: 109-116. [PubMed]
- [3] Marioni-Henry K, Van Winkle TJ, Smith SH et al.: Tumors affecting the spinal cord of cats: 85 cases (1980-2005). J Am Vet Med Assoc 2008; 232: 237-243. [PubMed]
- [4] Marioni-Henry K, Vite CH, Newton AL et al.: Prevalence of diseases of the spinal cord of cats. J Vet Intern Med 2004; 18: 851-858. [PubMed]
- [5] Marioni-Henry K. Feline spinal cord diseases. Vet Clin North Am Small Anim Pract 2010; 40(5): 1011-1028. [PubMed]
- [6] Rissi DR. A review of primary central nervous system neoplasms of cats. Vet Pathol 2023; 60(3): 294-307. [PubMed]
- [7] Spodnick GJ, Berg J, Moore FM et al.: Spinal lymphoma in cats: 21 cases (1976-1989). J Am Vet Med Assoc 1992; 200: 373-376. [PubMed]
- [8] Troxel MT, Vite CH, Van Winkle TJ et al.: Feline intracranial neoplasia: retrospective review of 160 cases (1985-2001). J Vet Intern Med 2003; 17: 850-859. [PubMed]
- [9] Mooney SC, Hayes AA: Lymphoma in the cat: an approach to diagnosis and management. Semin Vet Med Surg (Small Anim) 1986; 1: 51-57. [PubMed]
- [10] Lane SB, Kornegay JN, Duncan JR et al.: Feline spinal lymphosarcoma: a retrospective evaluation of 23 cats. J Vet Intern Med 1994; 8: 99-104. [PubMed]
- [11] Valli VE, Bienzle D, Meuten DJ. Tumors of the hemolymphatic system. En Meuten DJ (ed): Tumors in Domestic Animals. 5th ed. IA: John Wiley and Sons, 2017; 203-321.
- [12] Lorenzo V, Ribeiro J, Bernardini M, et al.: Clinical and magnetic resonance imaging features, and pathological findings of spinal lymphoma in 27 cats. Sci 2022; 9: 980414. [PubMed]
- [13] Zaki FA, Hurvitz AI: Spontaneous neoplasms of the central nervous system of the cat. J Small Anim Pract 1976; 17(12): 773-782. [PubMed]
- [14] Rissi DR, McHale BJ, Miller AD: Primary nervous system lymphoma in cats. J Vet Diagn Invest 2022; 20: 10406387221090281. [PubMed]
- [15] Palus V, Volk HA, Lamb CR, Targett MP, Cherubini GB: MRI features of CNS lymphoma in dogs and cats. Vet Radiol Ultrasound 2012; 53: 44-49. [PubMed]
- [16] Durand A, Keenihan E, Schweizer D, et al.: Clinical and magnetic resonance imaging features of lymphoma involving the nervous system in cats. J Vet Intern Med 2022; 36: 679-693. [PubMed]
- [17] Mello LS, Leite-Filho RV, Panziera W, et al.: Feline lymphoma in the nervous system: pathological, immunohistochemical, and etiological aspects in 16 cats. Pesq Vet Bras 2019; 39: 393-401.
- [18] Morrison WB, McCaw D, Cotter S, Ogilvie G, Moore A: The histologic classification of 602 cases of feline lymphoproliferative disease using the National Cancer Institute working formulation. J Vet Diagn Invest 2000; 12(4): 295-306. [PubMed]
- [19] Sato H, Yasuhito F, Junko C et al.: Prognostic analyses on anatomical and morphological classification of feline lymphoma. J Vet Med Sci 2014; 76: 807-811. [PubMed]
- [20] Moore A: Extranodal Lymphoma in the Cat: Prognostic factors and treatment options. J Feline Med Surg 2013; 15(5): 379-390. [PubMed]
- [21] Cugati G, Singh M, Pande A, et al.: Primary spinal epidural lymphomas. J Craniovertebr Junction Spine 2011; 2: 3-11. [PubMed]
- [22] Couto CG: Avances en el tratamiento del gato con linfoma en la práctica. Revista de Medicina y Cirugía Felina 2000; 2(2): 95-100.
- [23] Elmslie RE, Ogilvie GK, Gillette EL, McChesney-Gillette S: Radiotherapy with and without chemotherapy for localized lymphoma in 10 cats. Vet Radiol 1991; 32: 277-280.
- [24] Meleo KA. The role of radiotherapy in the treatment of lymphoma and thymoma. Vet Clin North Am Small Anim Pract 1997; 27(1): 115-129. [PubMed]
- [25] Taylor SS, Goodfellow MR, Browne WJ, et al.: Feline extranodal lymphoma: response to chemotherapy and survival in 110 cats. J Small Anim Pract 2009; 50(11): 584-592. [PubMed]
- [26] Fan TM, Kitchell BE, Dhaliwal RS, et al.: Hematological toxicity and therapeutic efficacy of lomustine in 20 tumor-bearing cats: critical assessment of a practical dosing regimen. J Am Anim Hosp Assoc 2002; 38(4): 357-363. [PubMed]
- [27] Rassnick KM, Gieger TL, Williams LE, et al.: Phase I evaluation of CCNU (lomustine) in tumor-bearing cats. J Vet Intern Med 2001; 15(3): 196-199. [PubMed]
- [28] Dutelle AL, Bulman-Fleming JC, Lewis CA, Rosenberg MP: Evaluation of lomustine as a rescue agent for cats with resistant lymphoma. J Feline Med Surg 2012; 14(10): 694-700. [PubMed]
- [29] Rau SE, Burgess KE: A retrospective evaluation of lomustine (CeeNU) in 32 treatment naïve cats with intermediate to large cell gastrointestinal lymphoma (2006-2013). Vet Comp Oncol 2017; 15(3): 1019-1028. [PubMed]
Artículos recomendados
Estas recomendaciones se ofrecen de forma automática.
-
Sarcoma histiocítico ocular felino
M.T. Artacho-Burgos, A. I. Raya-BermúdezClin Vet Peq Anim Vol. 45 - Nº 4 · DIC 2025 · Artículo original referido a un solo caso clínico
-
Tratamiento con pregabalina para la epilepsia refractaria felina
N. Delgado, S. Moya, L. García, et al.Clin Vet Peq Anim Vol. 44 - Nº 2 · JUN 2024 · Artículo original referido a múltiples casos clínicos -
Metástasis intramedular de un carcinoma mamario en un gato
A.M. Hernández-Guerra, P. Rojas, C. Puente, et al.Clin Vet Peq Anim Vol. 38 - Nº 1 · MAR 2018 · Artículo original referido a un solo caso clínico


